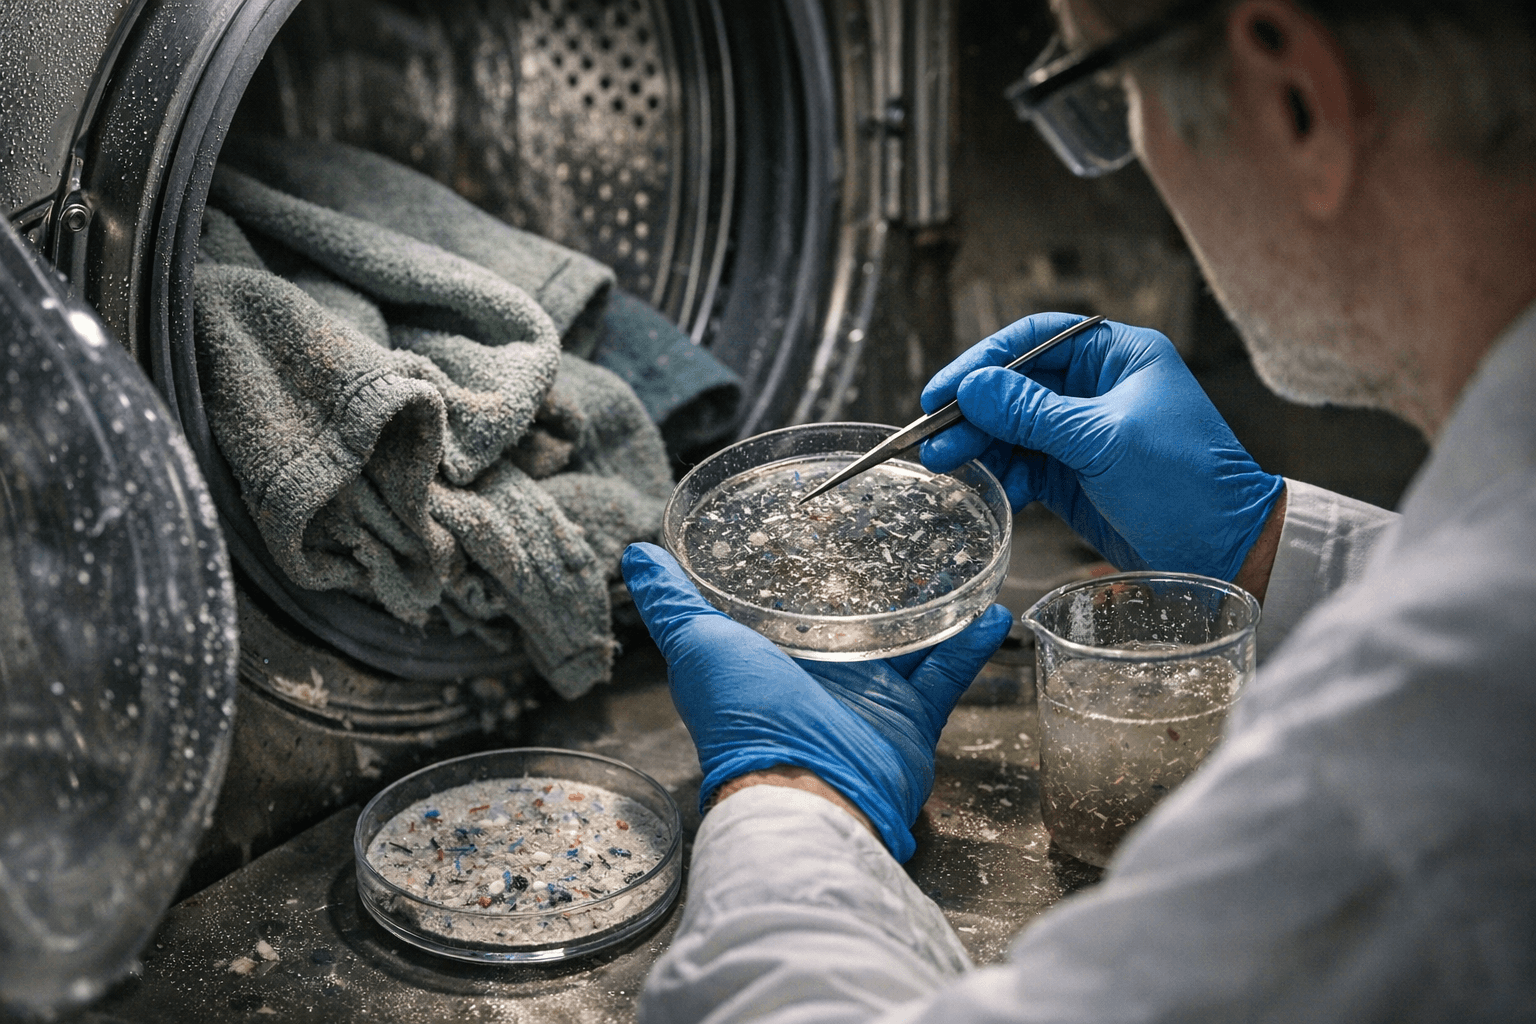
Recycled Fleece Sheds More Microfibers Than Virgin PET, Study Finds

Recycled Fleece Sheds More Microfibers Than Virgin PET, Study Finds
Recycled fleece shed 64% more microfibers than virgin PET on the first wash, a peer-reviewed study found, complicating fashion's recycled-plastic sustainability story.
The recycled-fleece story just got more complicated. A peer-reviewed study published in the Laundry & Textile Research Journal found that 100% recycled PET fleece shed measurably more microfibers during laundering than its virgin-polyester equivalent, handing regulators and manufacturers a data point that cuts against one of fashion's most-repeated sustainability talking points.
Lead researcher Xuejie Zhao and co-authors ran both fabrics through repeated wash cycles using AATCC TM212-2021, the industry's standardized test method for quantifying fiber fragment release during home laundering. The gap was sharpest at first wash: recycled PET fleece released 485 ± 42 mg of microfibers per kilogram of fabric, compared to 295 ± 25 mg/kg for virgin PET fleece. That's a 64% difference in first-wash shedding, not a rounding error.
The reason tracks with what materials science has been signaling for a while. When PET is melted down and re-spun, the resulting fibers tend to be more brittle than their original-run counterparts. Structural degradation built into the recycling process means the fiber breaks earlier and more easily under the mechanical stress of a wash drum. That brittleness is partly why rPET fleece shed harder out of the gate.
The data did soften over time. Shedding rates for both fabrics dropped steeply after those early wash cycles and eventually stabilized, suggesting that a garment's lifetime microfiber output is not simply six times its first-wash number. But that stabilization curve is exactly what makes the study's regulatory argument so pointed: a single-test disclosure, which is what most proposed compliance frameworks currently envision, would capture the worst-case moment for rPET and miss the fuller picture for both materials.
Zhao's team flagged direct implications for the EU's incoming microplastics rules and specifically for the Ecodesign for Sustainable Products Regulation, whose delegated act on textiles is expected around late 2026 or early 2027. Under ESPR's Digital Product Passport framework, manufacturers will eventually be required to disclose microfiber performance. The study argues that any such disclosure based on a single test value is structurally inadequate, because shedding dynamics shift significantly across the life of a garment. The researchers are pushing for wash-cycle-resolved reporting protocols instead.
For brands that built sustainability credentials on rPET fleece, specifically Patagonia's Synchilla line, Arc'teryx's recycled-poly mid-layers, and the broader wave of "made from plastic bottles" outerwear that defined the last decade of eco-marketing, this study doesn't erase the upstream environmental case for keeping bottles out of landfill. It does, however, demand a more honest accounting of what happens downstream, in the water supply, every time that jacket goes through a wash.
The takeaway for consumers who've been reaching for the rPET option as the clearly cleaner choice: the calculus is less clean than the hangtag implies. A high-quality fleece construction, regardless of feedstock, outperforms a poorly spun one on microfiber release. Recycled content matters, but so does how the fiber was processed, how tightly it was constructed, and whether a microfiber-catching laundry bag is anywhere near your washing machine.
Know something we missed? Have a correction or additional information?
Submit a Tip

